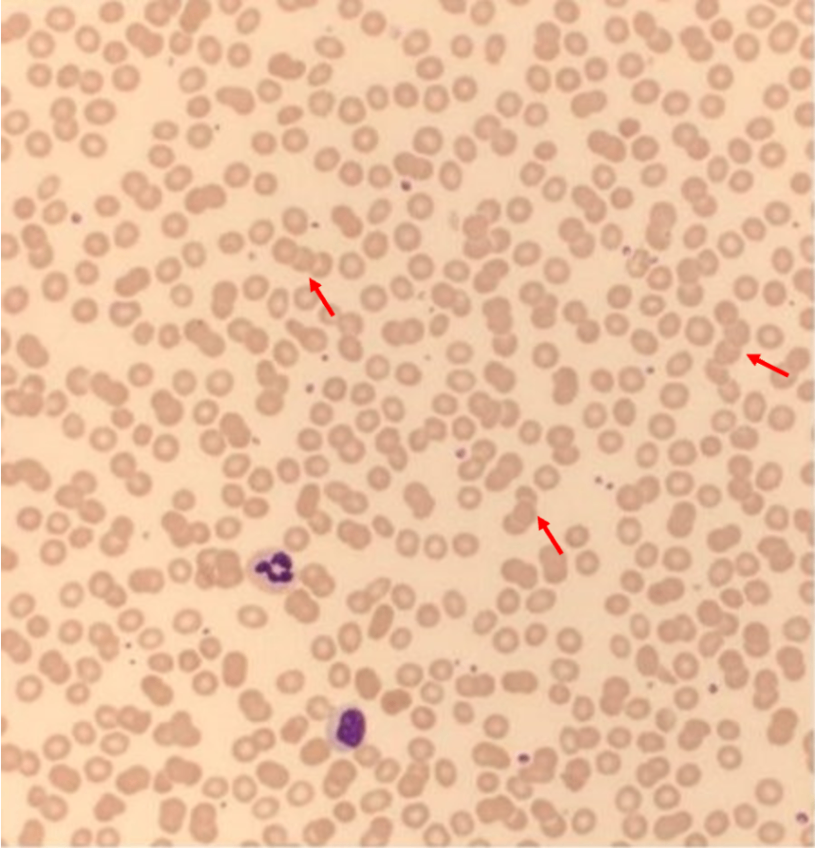

48번
[임종평24-1]
0
65세 남자가 1개월 전부터 허리통증으로 병원에 왔다. 혈압 130/80 mmHg, 맥박 88회/분, 호흡 16회/분, 체온 36.7 ℃이다. 양쪽 정강뼈앞 오목부종이 있다. 혈액검사 및 소변검사 결과는 다음과 같다. 말초혈액펴바른표본검사 사진과 자기공명영상 사진이다. 검사는?
혈액: 혈색소 8.2 g/dL, 백혈구 3,400/㎣, 혈소판 80,000/㎣, 총단백질 10.2 g/dL, 알부민 2.7 g/dL,
24 시간 소변: 단백질 9.8 g


정답률 84%
누적 풀이 횟수 2,700+
평균 풀이 시간38초
/
나의 풀이 시간0초
CC | M/65, 허리통증(1m) |
Hx | |
S/Sx | 허리통증 V/S 130/80 88 16 36.7, pretibial pitting edema (+/+) |
Lab | WBC↓, Hb↓, PLT↓, alb↓ U/A: UPCR 9,800mg/g |
Img | Spine MRI: Multiple well-defined lytic lesions |
Etc | PB smear: Rouleaux formation of erythrocytes |
Imp: 다발골수종(multiple myeloma, MM)
해설
허리통증을 주소로 내원한 환자로, albumin에 비해 매우 높은 total protein과 proteinuria, 설명되지 않는 anemia, spine MRI 상의 osteolytic lesion 등의 end-organ damage 소견을 통해 MM 의심 하 혈청 및 소변 단백질 전기영동을 시행한다.
• 65세 남자가 1개월 전부터 시작된 허리통증을 주호소로 내원하였다.
• 신체검진 상 양측 정강이의 오목부종, lab test 상 anemia, leukopenia, thrombocytopenia, hypoalbuminemia가 확인되며 24시간 요단백정량결과 9,800mg/g으로, nephrotic range의 proteinuria가 확인된다. 특히 albumin 수치에 비해 total protein 수치가 매우 높아 albumin 이외에 다수의 protein이 생성되고 있음을 의미한다. 이는 단일 클론의 형질세포가 증식하여 분비하는 immunoglobulin의 혈중 농도가 높아 나타나는 monoclonal gammopathy의 소견을 보임을 알 수 있다.
• CBC 이상소견으로 시행한 PB smear 결과 적혈구가 동전꾸러미처럼 배열된 양상인 Rouleaux foramation을 확인할 수 있으며 이는 immunoglobulin의 혈중농도가 높은 monoclonal gammopathy, chronic infection 등에서 나타나는 현상이다. 이는 양전하를 띠는 혈중 단백이 음전하를 띠는 적혈구의 표면을 coating하여 neutralization되고, 적혈구 간의 척력이 사라짐에 따라 적혈구가 쌓일 수 있게 되어 형성되는 구조이다.
• 앞서 CBC에서 확인할 수 있었던 anemia 소견과 더불어 허리통증의 감별을 위한 spine MRI 결과 다수의 osteolytic lesion을 종합했을 때 타기관 침범에 따른 손상이 발생하였음을 알 수 있으며, monoclonal gammopathy 중 MM에 해당하는 소견임을 알 수 있다. 본 증례에서는 BUN/Cr을 측정하지 않았으나 환자에게서 나타난 양측의 오목부종 소견 또한 신기능의 손상으로 인한 fluid retention의 결과일 가능성이 높다.
• 종합하였을 때 MM을 진단하기 위해서는 M protein을 확인하기 위한 혈청 및 소변 단백질 전기영동 검사를 시행하여야 하며, 골수에 plasma cell이 얼마나 침범했는지 확인하기 위한 골수흡인생검 검사를 시행하여야 한다.
Tip
• Monoclonal gammopathy는 혈중 M protein의 농도와 bone marrow 침범여부, 타기관 침범에 따른 손상여부(related organ or tissue impairment, ROTI)에 따라 monoclonal gammopathy of undetermined significance(MGUS), smoldering myeloma(SMM), multiple myeloma(MM)로 나뉘며 다른 두 질환과는 달리 MM은 타기관 침범에 따른 손상이 나타난다는 점이 특징적이다. 이에 나타날 수 있는 특징적 소견은 hypercalcemia, renal insufficiency, anemia, bone lesion으로 흔히 CRAB으로 암기한다.
• MM에 의해 나타나는 특징적 소견의 앞글자를 딴 CRAB(HyperCalcemia, Renal insufficiency, Anemia, Bone lesion)를 반드시 기억해야한다.
• 단백질 전기영동 검사를 통해 찾아내는 M protein은 plasma cell의 단일클론증식으로 인해 분비되는 비정상적인 immunoglobulin으로 monoclonal protein으로 불리기도 한다. 단일클론에서 과생성된 protein은 모두 동일하기 때문에 전하 또한 동일하여 전기영동에서 마치 spike처럼 나타난다는 특징을 보여 이를 'M spike'라고 한다.
오답 선지
• 뼈스캔: MM의 bone lesion은 osteolytic change에 의한 것이며, 뼈스캔은 뼈를 생성하는 osteoblastic activity를 보기 위해 시행하는 검사이므로 적절하지 않다.
• 뇌척수액검사: 환자의 허리통증은 bone의 lytic lesion에 의한 것으로 뇌척수액과는 무관하다. 따라서 본 증례에서 뇌척수액 검사는 적절하지 않다.
• 신장조직검사: 환자가 부종, hypoalbunemia, nephrotic range의 proteinuria를 보여 nephrotic syndrome의 가능성을 고려할 수 있겠으나 lab test와 임상상을 통해 multiple myeloma가 가장 강력히 의심되는 상황이므로 우선적으로 multiple myeloma를 감별하기 위한 진단적 검사를 하는 것이 적절하다.
• 양전자방출단층촬영-컴퓨터단층촬영: PET-CT는 metastatic lesion을 확인하기 위해 시행할 수 있는 검사로, multiple myeloma가 가장 강력히 의심되는 상황이므로 우선적으로 multiple myeloma를 감별하기 위한 진단적 검사를 하는 것이 적절하다.
관련 이론
• 다발골수종 및 기타 혈액암
Reference
• Harrison 21e, pp.866-878